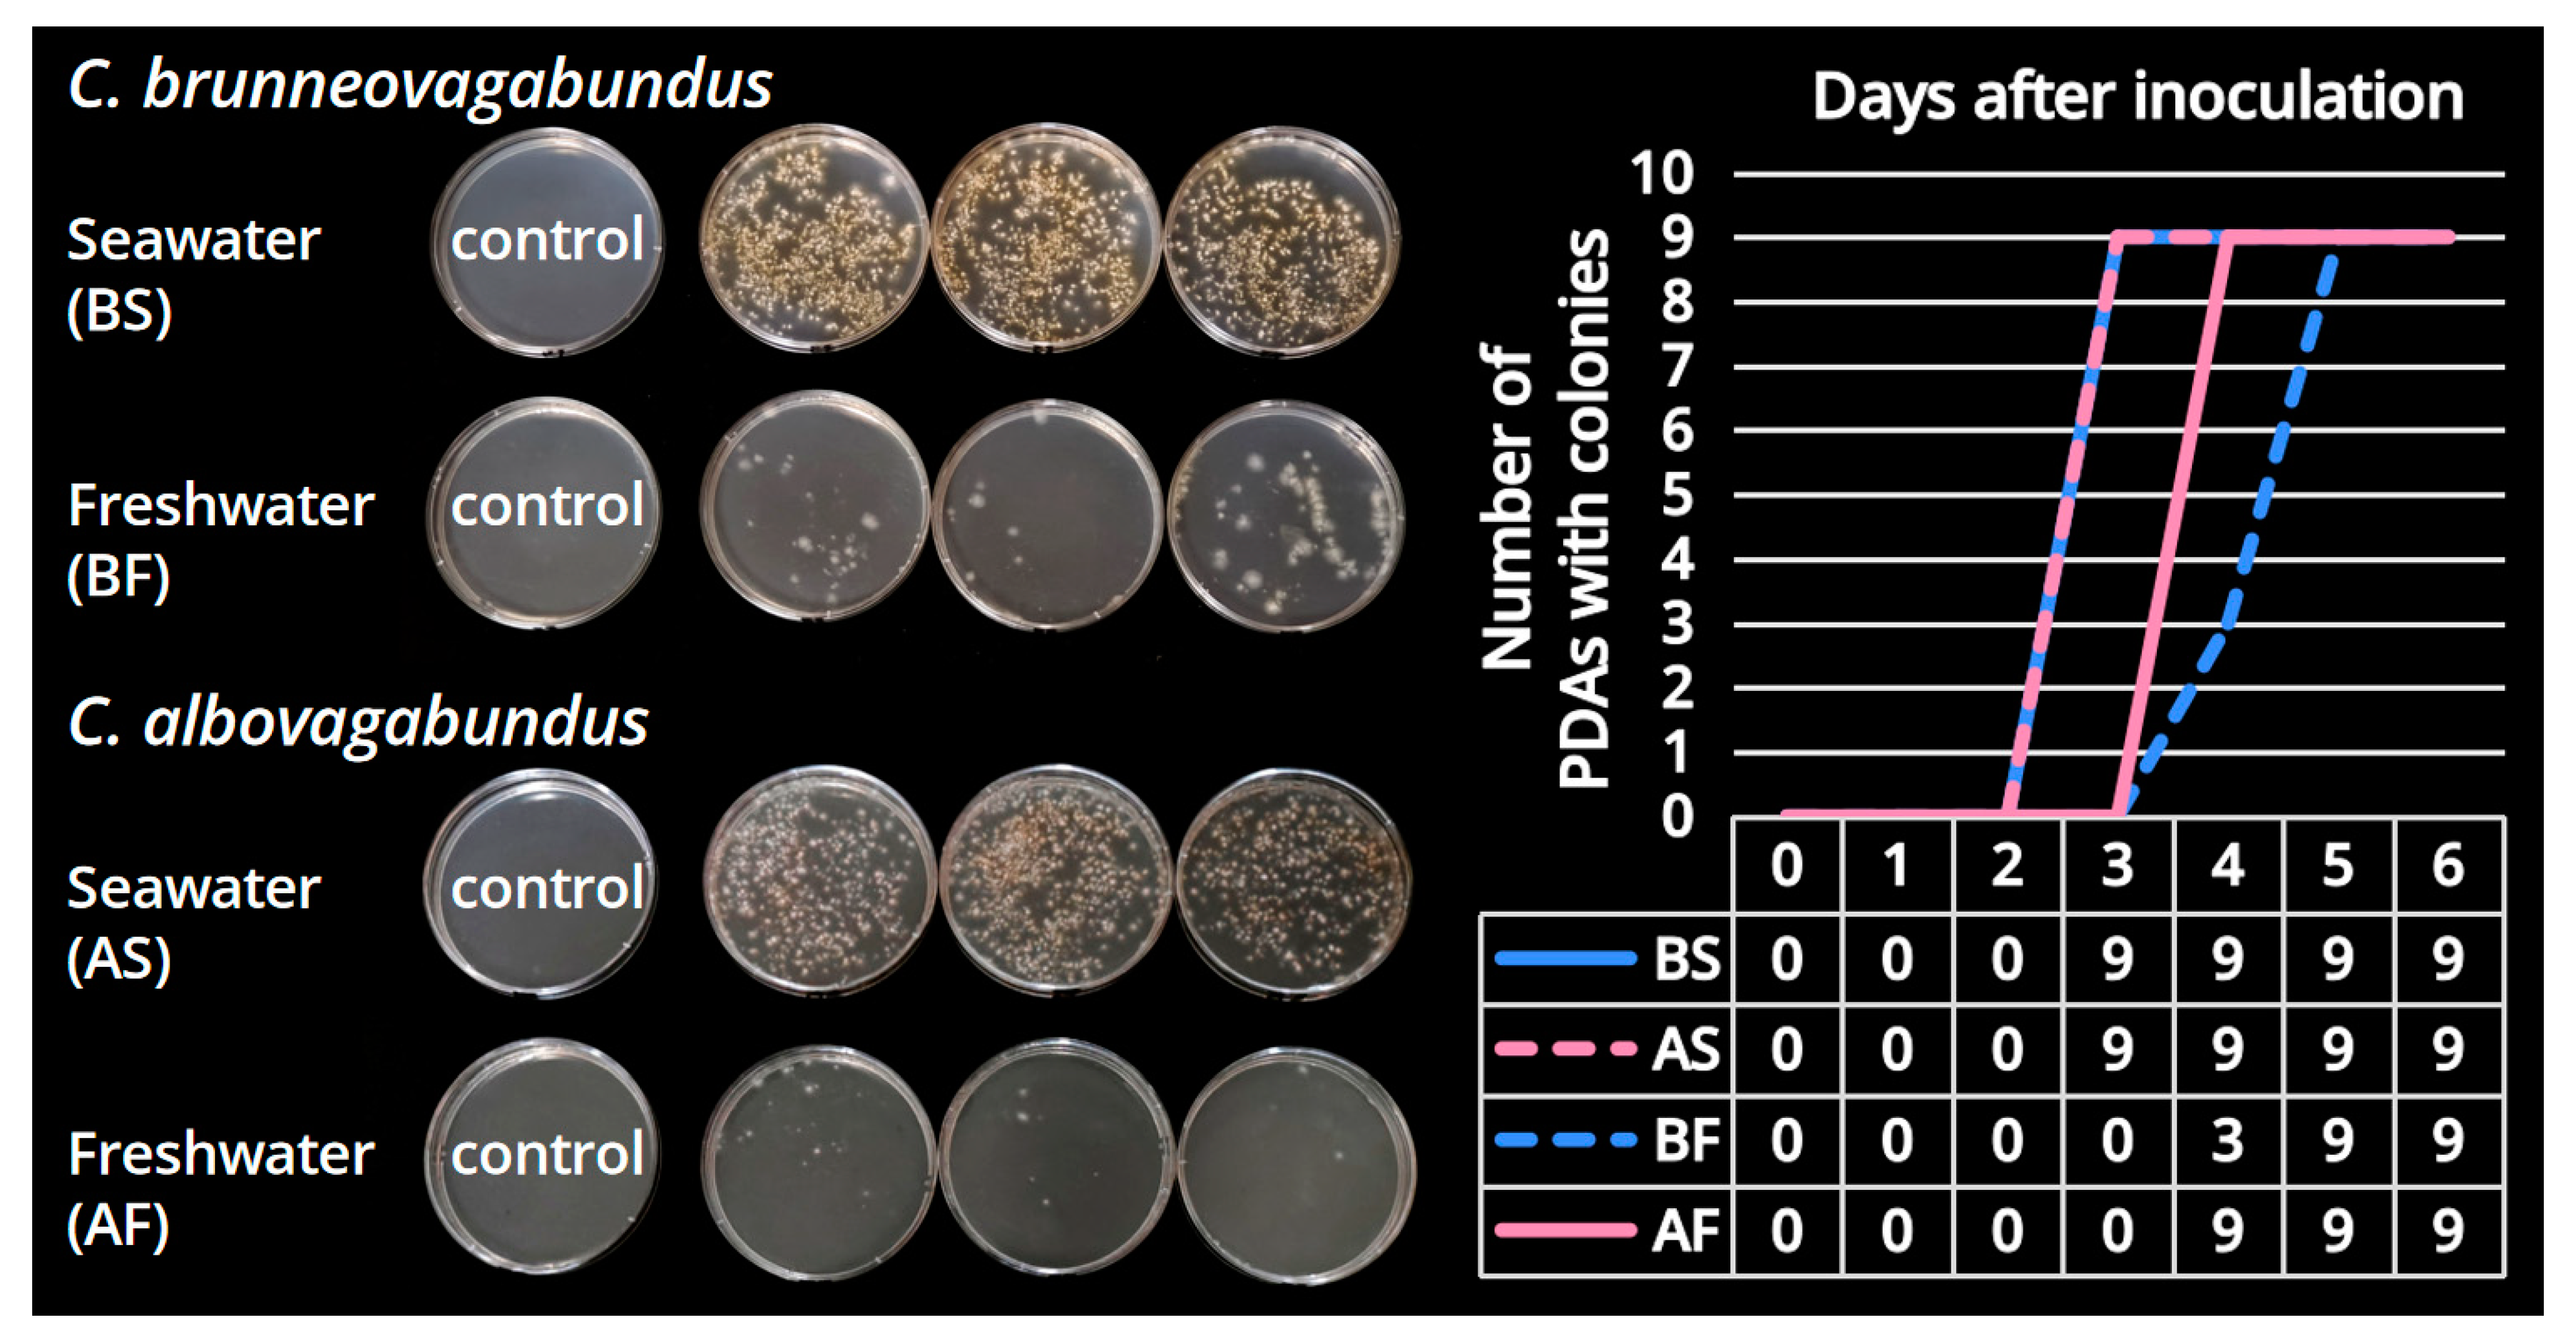
Jof 09 01204 g005 Jof 09 01204 g005

Mushrooms Adapted to Seawater: Two New Species of Candolleomyces (Basidiomycota, Agaricales) from China
Abstract
1. Introduction
2. Materials and Methods
2.1. Specimen Collection
2.2. Morphological and Ecological Observations
2.3. Contrast Culturing
2.3.1. Spore Suspensions Making
2.3.2. Media Preparing
2.3.3. Culturing and Data Recording
2.4. Molecular Sequencing
2.5. Phylogenetic Analysis
3. Results
3.1. Morphological and Ecological Observations
3.1.1. Morphological Characteristics
3.1.2. The Droppable Pileus-Gleba-Inner Veil Complex (PGI)
3.1.3. Ecological Habits
3.2. Contrast Culturing
3.3. Phylogenetic Analysis
3.4. Taxonomy
4. Discussion
4.1. Two New Species of Candolleomyces
4.2. A New Lineage of Marine Basidiomycetes
4.3. Are They Native to the Collection Sites?
4.4. Further Testing of the Salt Tolerance
Supplementary Materials
Author Contributions
Funding
Institutional Review Board Statement
Informed Consent Statement
Data Availability Statement
Acknowledgments
Conflicts of Interest
References
- Cunliffe, M. Who are the marine fungi? Environ. Microbiol. 2023, 25, 131–134. [Google Scholar] [CrossRef] [PubMed]
- Pang, K.L.; Overy, D.P.; Jones, E.B.G.; Calado, M.L.; Burgaud, G.; Walker, A.K.; Johnson, J.A.; Kerr, R.G.; Cha, H.J.; Bills, G.F. “Marine fungi” and “marine-derived fungi” in natural product chemistry research: Toward a new consensual definition. Fungal Biol. Rev. 2016, 30, 163–175. [Google Scholar] [CrossRef]
- Wijayawardene, N.N.; Dai, D.Q.; Jayasinghe, P.K.; Gunasekara, S.S.; Nagano, Y.; Tibpromma, S.; Suwannarach, N.; Boonyuen, N. Ecological and oceanographic perspectives in future marine fungal taxonomy. J. Fungi 2022, 8, 1141. [Google Scholar] [CrossRef] [PubMed]
- Hyde, K.D.; Lee, S.Y. Ecology of mangrove fungi and their role in nutrient cycling: What gaps occur in our knowledge? Hydrobiologia 1995, 295, 107–118. [Google Scholar] [CrossRef]
- Jones, E.B.G.; Sakayaroj, J.; Suetrong, S.; Somrithipol, S.; Pang, K.L. Classification of marine Ascomycota, anamorphic taxa and Basidiomycota. Fungal Divers. 2009, 35, 1–187. [Google Scholar]
- Peng, H.Y.; Xu, J.; Wang, Y.; Yu, L. Advances in the diversity of marine fungi in mangrove wetlands. J. Fungal Res. 2012, 10, 265–270. [Google Scholar] [CrossRef]
- Shin, H.J. Natural products from marine fungi. Mar. Drugs 2020, 18, 230. [Google Scholar] [CrossRef]
- Hatai, K. Diseases of fish and shellfish caused by marine fungi. Prog. Mol. Subcell. Biol. 2012, 53, 15–52. [Google Scholar] [CrossRef]
- Huggins, J.L.; Garner, M.M.; Raverty, S.A.; Lambourn, D.M.; Norman, S.A.; Rhodes, L.D.; Gaydos, J.K.; Olson, J.K.; Haulena, M.; Hanson, M.B. The emergence of mucormycosis in free-ranging marine mammals of the pacific northwest. Front. Mar. Sci. 2020, 7, 555. [Google Scholar] [CrossRef]
- Jones, E.B.G.; Pang, K.L.; Abdel-Wahab, M.A.; Scholz, B.; Hyde, K.D.; Boekhout, T.; Ebel, R.; Rateb, M.E.; Henderson, L.; Sakayaroj, J.; et al. An online resource for marine fungi. Fungal Divers. 2019, 96, 347–433. [Google Scholar] [CrossRef]
- Calabon, M.; Jones, E.B.G.; Pang, K.; Abdel-Wahab, M.; Jin, J.; Devadatha, B.; Sadaba, R.; Apurillo, C.; Hyde, K. Updates on the classification and numbers of marine fungi. Bot. Mar. 2023, 66, 213–238. [Google Scholar] [CrossRef]
- Zieniuk, B.; Fabiszewska, A. Yarrowia lipolytica: A beneficious yeast in biotechnology as a rare opportunistic fungal pathogen: A minireview. World J. Microbiol. 2018, 35, 10. [Google Scholar] [CrossRef] [PubMed]
- Tharp, T.P.; Bland, C.E. Biology and host range of Haliphthoros milfordensis. Can. J. Bot. 1977, 55, 2936–2944. [Google Scholar] [CrossRef]
- Lee, S.J.; Yokoyama, H.; Ogawa, K. Modes of transmission of Glugea plecoglossi (Microspora) via the skin and digestive tract in an experimental infection model using rainbow trout, Oncorhynchus mykiss (Walbaum). J. Fish Dis. 2004, 27, 435–444. [Google Scholar] [CrossRef] [PubMed]
- Dayarathne, M.C.; Jones, E.B.G.; Maharachchikumbura, S.S.N.; Devadatha, B.; Sarma, V.V.; Khongphinitbunjong, K.; Chomnunti, P.; Hyde, K.D. Morpho-molecular characterization of microfungi associated with marine based habitats. Mycosphere 2020, 11, 1–188. [Google Scholar] [CrossRef]
- Spatafora, J.W.; Volkmann-Kohlmeyer, B.; Kohlmeyer, J. Independent terrestrial origins of the Halosphaeriales (marine Ascomycota). Am. J. Bot. 1998, 85, 1569–1580. [Google Scholar] [CrossRef] [PubMed]
- Zhang, Y.; Schoch, C.L.; Fournier, J.; Crous, P.W.; de Gruyter, J.; Woudenberg, J.H.; Hirayama, K.; Tanaka, K.; Pointing, S.B.; Spatafora, J.W.; et al. Multi-locus phylogeny of Pleosporales: A taxonomic, ecological and evolutionary re-evaluation. Stud. Mycol. 2009, 64, 85–102. [Google Scholar] [CrossRef]
- Amend, A.; Burgaud, G.; Cunliffe, M.; Edgcomb, V.P.; Ettinger, C.L.; Gutiérrez, M.H.; Heitman, J.; Hom, E.F.Y.; Ianiri, G.; Jones, A.C.; et al. Fungi in the marine environment: Open questions and unsolved problems. mBio 2019, 10, e01189-18. [Google Scholar] [CrossRef]
- Jones, E.B.G. Are there more marine fungi to be described? Bot. Mar. 2011, 54, 343–354. [Google Scholar] [CrossRef]
- Pang, K.L.; Jheng, J.S.; Jones, E.B.G. Marine Mangrove Fungi of Taiwan, 1st ed.; National Taiwan Ocean University: Keelung, Taiwan, 2011; pp. 1–131. [Google Scholar]
- Abdel-Wahab, M.A.; Jones, E.B.G.; Abdel-Aziz, F.A.; Bahkali, A.H. Nia lenicarpa sp. nov. (Niaceae, Agaricales) from Red Sea mangroves in Saudi Arabia with comments on Nia vibrissa. Phytotaxa 2019, 406, 157–168. [Google Scholar] [CrossRef]
- Binder, M.; Hibbett, D.S.; Molitoris, H.P. Phylogenetic relationships of the marine gasteromycete Nia vibrissa. Mycologia 2001, 93, 679–688. [Google Scholar] [CrossRef]
- Binder, M.; Hibbett, D.S.; Wang, Z.; Farnham, W.F. Evolutionary relationships of Mycaureola dilseae (Agaricales), a basidiomycete pathogen of a subtidal rhodophyte. Am. J. Bot. 2006, 93, 547–556. [Google Scholar] [CrossRef] [PubMed]
- Hibbett, D.S.; Binder, M. Evolution of marine mushrooms. Biol. Bull. 2001, 201, 319–322. [Google Scholar] [CrossRef] [PubMed][Green Version]
- Hyde, K.D.; Jones, E.B.G.; Leano, L.; Pointing, S.B.; Poonyth, A.D.; Vrijmoed, L.L.E. Role of fungi in marine ecosystems. Biodivers. Conserv. 1998, 7, 1147–1161. [Google Scholar] [CrossRef]
- Nakagiri, A.; Ito, T. Basidiocarp development of the cyphelloid gasteroid aquatic basidiomycetes Halocyphina villosa and Limnoperdon incarnatum. Can. J. Bot. 1991, 69, 2320–2327. [Google Scholar] [CrossRef]
- Jones, E.B.G.; Agerer, R. Calathella mangrovei sp. nov. and observations on the mangrove fungus Halocyphina villosa. Bot. Mar. 1992, 35, 259–266. [Google Scholar] [CrossRef]
- Jones, E.B.G. Digitatispora lignicola, a new lignicolous Basidiomycotina. Mycotaxon 1986, 27, 155–159. [Google Scholar]
- Rämä, T.; Mathiassen, G.H.; Kauserud, H. Marine fungi new to Norway, with an outlook to the overall diversity. Agarica 2014, 35, 35–47. [Google Scholar]
- Rosello, M.A.; Descals, E.; Cabrer, B. Nia epidermoidea, a new marine gasteromycete. Mycol. Res. 1993, 97, 68–70. [Google Scholar] [CrossRef]
- Sakayaroj, J.; Supaphon, O.; Jones, E.B.G.; Phongpaichit, S. Diversity of higher marine fungi at Hat Khanom-Mu Ko Thale Tai National Park, Southern Thailand. Songklanakarin J. Sci. Technol. 2011, 33, 15–22. [Google Scholar]
- Jones, E.B.G.; Choeyklin, R. Ecology of marine and freshwater basidiomycetes. Br. Mycol. Soc. Symp. 2008, 28, 301–324. [Google Scholar] [CrossRef]
- Inderbitzin, P.; Desjardin, D.E. A new halotolerant species of Physalacria from Hong Kong. Mycologia 1999, 91, 666–668. [Google Scholar] [CrossRef]
- Hattori, T.; Sakayaroj, J.; Jones, E.B.G.; Suetrong, S.; Preedanon, S.; Klaysuban, A. Three species of Fulvifomes (Basidiomycota, Hymenochaetales) associated with rots on mangrove tree Xylocarpus granatum in Thailand. Mycoscience 2014, 55, 344–354. [Google Scholar] [CrossRef]
- Maekawa, N.; Suhara, H.; Kinjo, K.; Kondo, R.; Hoshi, Y. Haloaleurodiscus mangrovei gen. sp. nov. (Basidiomycota) from mangrove forests in Japan. Mycol. Res. 2005, 109, 825–832. [Google Scholar] [CrossRef] [PubMed]
- Jones, E.B.G.; Suetrong, S.; Sakayaroj, J.; Bahkali, A.H.; Abdel-Wahab, M.A.; Boekhout, T.; Pang, K. Classification of marine Ascomycota, Basidiomycota, Blastocladiomycota and Chytridiomycota. Fungal Divers. 2015, 73, 1–72. [Google Scholar] [CrossRef]
- Jia, M.M.; Wang, Z.M.; Mao, D.H.; Huang, C.L.; Lu, C.Y. Spatial-temporal changes of China’s mangrove forests over the past 50 years: An analysis towards the Sustainable Development Goals (SDGs). Chin. Sci. Bull. 2021, 66, 3886–3901. (In Chinese) [Google Scholar] [CrossRef]
- Jia, S.L.; Chi, Z.; Liu, G.L.; Hu, Z.; Chi, Z.M. Fungi in mangrove ecosystems and their potential applications. Crit. Rev. Biotechnol. 2020, 40, 852–864. [Google Scholar] [CrossRef]
- Yang, K.L. Towards a standardized expression system of colors in fungal morphological description: Color nomenclatural code for description works of specimens in Kun L. Yang’s private herbarium (HTBM). Zenodo 2023. Personal article. [Google Scholar] [CrossRef]
- Gardes, M.; Bruns, T.D. ITS primers with enhanced specificity for Basidiomycetes: Application to identification of mycorrhizae and rusts. Mol. Ecol. 1993, 2, 113–118. [Google Scholar] [CrossRef]
- White, T.J.; Bruns, T.D.; Lee, S.; Taylor, J. Amplification and direct sequencing of fungal ribosomal RNA genes for phylogenetics. In PCR Protocols, a Guide to Methods and Applications, 1st ed.; Innis, M.A., Gelfand, D.H., Sninsky, J.J., White, T.J., Eds.; Academic Press: California, MA, USA, 1990; pp. 315–322. [Google Scholar] [CrossRef]
- Vilgalys Mycology Lab—Duke University. Available online: https://sites.duke.edu/vilgalyslab (accessed on 1 November 2023).
- Rehner, S.A.; Buckley, E. A Beauveria phylogeny inferred from nuclear ITS and EF1-α sequences: Evidence for cryptic diversification and links to Cordyceps teleomorphs. Mycologia 2005, 97, 84–98. [Google Scholar] [CrossRef]
- Nagy, L.G.; Walther, G.; Házi, J.; Vágvölgyi, C.; Papp, T. Understanding the evolutionary processes of fungal fruiting bodies: Correlated evolution and divergence times in the Psathyrellaceae. Syst. Biol. 2011, 60, 303–317. [Google Scholar] [CrossRef]
- Cai, Q.; Tulloss, R.E.; Tang, L.P.; Tolgor, B.; Zhang, P.; Chen, Z.H.; Yang, Z.L. Multi-locus phylogeny of lethal amanitas: Implications for species diversity and historical biogeography. BMC Evol. Biol. 2014, 14, 143. [Google Scholar] [CrossRef] [PubMed]
- Chromas. Available online: https://technelysium.com.au/wp/chromas (accessed on 1 November 2023).
- Kumar, S.; Stecher, G.; Tamura, K. MEGA7: Molecular evolutionary genetics analysis version 7.0 for bigger datasets. Mol. Biol. Evol. 2016, 33, 1870–1874. [Google Scholar] [CrossRef] [PubMed]
- Basic Local Alignment Search Tool. Available online: https://blast.ncbi.nlm.nih.gov/Blast.cgi (accessed on 1 November 2023).
- Voto, P.; Lee, S.M.L.; Dibán, M.J.; Maraia, G. Rachipsathyra, a new genus in Psathyrellaceae—Part I. Mycol. Obs. 2022, 4, 11–12. [Google Scholar]
- Katoh, K.; Standley, D.M. MAFFT multiple sequence alignment software version 7: Improvements in performance and usability. Mol. Biol. Evol. 2013, 30, 772–780. [Google Scholar] [CrossRef] [PubMed]
- Chen, C.; Wu, Y.; Li, J.; Wang, X.; Zeng, Z.; Xu, J.; Liu, Y.; Feng, J.; Chen, H.; He, Y.; et al. TBtools-II: A “One for all, all for one” bioinformatics platform for biological big-data mining. Mol. Plant. 2023, 16, 1733–1742. [Google Scholar] [CrossRef] [PubMed]
- Wächter, D.; Melzer, A. Proposal for a subdivision of the family Psathyrellaceae based on a taxon-rich phylogenetic analysis with iterative multigene guide tree. Mycol. Prog. 2020, 19, 1151–1265. [Google Scholar] [CrossRef]
- Xiang, C.Y.; Gao, F.L.; Jakovlić, I.; Lei, H.P.; Hu, Y.; Zhang, H.; Zou, H.; Wang, G.T.; Zhang, D. Using PhyloSuite for molecular phylogeny and tree-based analyses. iMeta 2023, 2, e87. [Google Scholar] [CrossRef]
- Zhang, D.; Gao, F.; Jakovlić, I.; Zou, H.; Zhang, J.; Li, W.X.; Wang, G.T. PhyloSuite: An integrated and scalable desktop platform for streamlined molecular sequence data management and evolutionary phylogenetics studies. Mol. Ecol. Resour. 2020, 20, 348–355. [Google Scholar] [CrossRef]
- Wang, S.N.; Fan, Y.G.; Yan, J.Q. Iugisporipsathyra reticulopilea gen. et sp. nov. (Agaricales, Psathyrellaceae) from tropical China produces unique ridge-ornamented spores with an obvious suprahilar plage. MycoKeys 2022, 90, 147–162. [Google Scholar] [CrossRef]
- Edler, D.; Klein, J.; Antonelli, A.; Silvestro, D. RaxmlGUI 2.0: A graphical interface and toolkit for phylogenetic analyses using RAxML. Methods Ecol. Evol. 2020, 12, 373–377. [Google Scholar] [CrossRef]
- FigTree. Available online: http://tree.bio.ed.ac.uk/software/figtree (accessed on 1 November 2023).
- Moreno, G.; Heykoop, M.; Esqueda, M.; Olariaga, I. Another lineage of secotioid fungi is discovered: Psathyrella secotioides sp. nov. from Mexico. Mycol. Prog. 2015, 14, 34. [Google Scholar] [CrossRef]
- Broussal, M.; Carbó, J.; Mir, G.; Pérez-De-Gregorio, M.À. Psathyrella salina, nouvelle espèce des milieux halophiles méditerranéens. Bull. Fed. Assoc. Mycol. Mediterr. 2018, 53, 17–30. [Google Scholar]
- Esteve-Raventós, F.; Enderle, M. Psathyrella halophila spec. nov., eine neue Art aus der Sektion Spintrigerae (Fr.) Konrad & Maublanc vom Meeresstrand der Insel Mallorca (Spanien). Z. Mykol. 1992, 58, 205–210. [Google Scholar]
- Lebel, T.; Davoodian, N.; Bloomfield, M.C.; Syme, K.; May, T.W.; Hosaka, K.; Castellano, M.A. A mixed bag of sequestrate fungi from five different families: Boletaceae, Russulaceae, Psathyrellaceae, Strophariaceae, and Hysterangiaceae. Swainsona 2022, 36, 33–65. [Google Scholar]
- Buller, A.H.R. Researches on Fungi. Volume VI, 1st ed.; Longmans, Green & Comp: London, UK, 1934; pp. 1–513. [Google Scholar]
- Escobar, G.A.; McCabe, D.E.; Harpel, C.W. Limnoperdon, a floating gasteromycete isolated from marshes. Mycologia 1976, 68, 874–880. [Google Scholar] [CrossRef]
- Gilbert, C.R. Geographic distribution of the striped mullet (Mugil cephalus Linnaeus) in the Atlantic and eastern Pacific Oceans. Fla. Sci. 1993, 56, 204–210. [Google Scholar]
- Yang, K.L. Mushrooms in the Field, 1st ed.; Guangdong People’s Publishing House: Guangzhou, China, 2019; pp. 1–224. (In Chinese) [Google Scholar]
- Coffan, R.A.; Frank, J.L.; Southworth, D. Aquatic gilled mushrooms: Psathyrella fruiting in the Rogue River in southern Oregon. Mycologia 2010, 102, 93–107. [Google Scholar]
- Cai, S.L. Phase II planning and design of Shenzhen West Bay Mangrove Park. Landsc. Archit. Pract. 2020, 42, 46–51. (In Chinese) [Google Scholar]
- Wang, R.J.; Chen, Z.Y. Systematics and biogeography study on the family Sonneratiaceae. Guihaia 2002, 22, 214–219. (In Chinese) [Google Scholar]
- Chen, Y.J.; Liao, B.W.; Peng, Y.Q.; Xu, S.K.; Zheng, S.F.; Zheng, D.Z. Researches on the northern introduction of mangrove species Sonneratia apetala. Guangdong For. Sci. Technol. 2003, 19, 9–12. (In Chinese) [Google Scholar]
- Zheng, D.Z.; Liao, B.W.; Zheng, S.F. Studies on the Techniques of Afforestation and Management of Main Mangrove Species, 1st ed.; Science Press: Beijing, China, 1999; pp. 1–365. (In Chinese) [Google Scholar]
- Gunde-Cimerman, N.; Frisvad, J.C.; Zalar, P.; Plemenitas, A. Halotolerant and halophilic fungi. In Biodiversity of Fungi—Their Role in Human Life, 1st ed.; Deshmukh, S.K., Rai, M.K., Eds.; Oxford & IBH Publishing Co. Pvt. Ltd.: New Delhi, India, 2005; pp. 69–128. [Google Scholar]
- Gunde-Cimerman, N.; Ramos, J.; Plemenitas, A. Halotolerant and halophilic fungi. Mycol. Res. 2009, 113, 1231–1241. [Google Scholar] [CrossRef] [PubMed]
- National Platform for Common Geospatial Information Services. Available online: https://www.tianditu.gov.cn (accessed on 1 November 2023).
- Izhar, A.; Asif, M.; Khan, Z.; Khalid, A.N. Introducing two new members of the genus Candolleomyces (Agaricales, Psathyrellaceae) from Punjab, Pakistan. Plant Syst. Evol. 2023, 309, 40. [Google Scholar] [CrossRef]
- Asif, M.; Izhar, A.; Niazi, A.R.; Khalid, A.N. Candolleomyces asiaticus sp. nov. (Psathyrellaceae, Agaricales), a novel species from Punjab, Pakistan. Eur. J. Taxon. 2022, 826, 176–187. [Google Scholar] [CrossRef]
- Zhou, H.; Cheng, G.Q.; Sun, X.M.; Cheng, R.Y.; Zhang, H.L.; Dong, Y.M.; Hou, C.L. Three new species of Candolleomyces (Agaricomycetes, Agaricales, Psathyrellaceae) from the Yanshan Mountains in China. MycoKeys 2022, 88, 109–121. [Google Scholar] [CrossRef] [PubMed]
- Haqnawaz, M.; Niazi, A.R.; Khalid, A.N. A study on the genus Candolleomyces (Agaricales: Psathyrellaceae) from Punjab, Pakistan. BMC Microbiol. 2023, 23, 181. [Google Scholar] [CrossRef] [PubMed]
- Bhunjun, C.S.; Niskanen, T.; Suwannarach, N.; Wannathes, N.; Chen, Y.J.; McKenzie, H.C.; Maharachchikumbura, S.S.N.; Buyck, B.; Zhao, C.L.; Fan, Y.G.; et al. The numbers of fungi: Are the most speciose genera truly diverse? Fungal Divers. 2022, 114, 387–462. [Google Scholar] [CrossRef]
- Nie, C.; Wang, S.N.; Tkalčec, Z.; Yan, J.Q.; Hu, Y.; Ge, Y.; Na, Q.; Zeng, H.; Ding, H.; Huo, G.; et al. Coprinus leucostictus Rediscovered after a century, epitypified, and its generic position in Hausknechtia resolved by multigene phylogenetic analysis of Psathyrellaceae. Diversity 2022, 14, 699. [Google Scholar] [CrossRef]
- Bau, T.; Yan, J.Q. A new genus and four new species in the/Psathyrella s.l. clade from China. MycoKeys 2021, 80, 115–131. [Google Scholar] [CrossRef]
- Zhu, L.Y.; Huang, M.; Bau, T. Taxonomy of coprinoid fungi in China. Mycosystema 2022, 41, 878–898. (In Chinese) [Google Scholar] [CrossRef]
- Wang, S.N.; Hu, Y.P.; Chen, J.L.; Qi, L.L.; Zeng, H.; Ding, H.; Huo, G.H.; Zhang, L.P.; Chen, F.S.; Yan, J.Q. First record of the rare genus Typhrasa (Psathyrellaceae, Agaricales) from China with description of two new species. MycoKeys 2021, 79, 119–128. [Google Scholar] [CrossRef] [PubMed]

Disclaimer/Publisher’s Note: The statements, opinions and data contained in all publications are solely those of the individual author(s) and contributor(s) and not of MDPI and/or the editor(s). MDPI and/or the editor(s) disclaim responsibility for any injury to people or property resulting from any ideas, methods, instructions or products referred to in the content. |
© 2023 by the authors. Licensee MDPI, Basel, Switzerland. This article is an open access article distributed under the terms and conditions of the Creative Commons Attribution (CC BY) license (https://creativecommons.org/licenses/by/4.0/).
Share and Cite
Yang, K.L.; Lin, J.Y.; Li, G.-M.; Yang, Z.L. Mushrooms Adapted to Seawater: Two New Species of Candolleomyces (Basidiomycota, Agaricales) from China. J. Fungi 2023, 9, 1204. https://doi.org/10.3390/jof9121204
Yang KL, Lin JY, Li G-M, Yang ZL. Mushrooms Adapted to Seawater: Two New Species of Candolleomyces (Basidiomycota, Agaricales) from China. Journal of Fungi. 2023; 9(12):1204. https://doi.org/10.3390/jof9121204
Chicago/Turabian StyleYang, Kun L., Jia Y. Lin, Guang-Mei Li, and Zhu L. Yang. 2023. "Mushrooms Adapted to Seawater: Two New Species of Candolleomyces (Basidiomycota, Agaricales) from China" Journal of Fungi 9, no. 12: 1204. https://doi.org/10.3390/jof9121204
APA StyleYang, K. L., Lin, J. Y., Li, G.-M., & Yang, Z. L. (2023). Mushrooms Adapted to Seawater: Two New Species of Candolleomyces (Basidiomycota, Agaricales) from China. Journal of Fungi, 9(12), 1204. https://doi.org/10.3390/jof9121204

